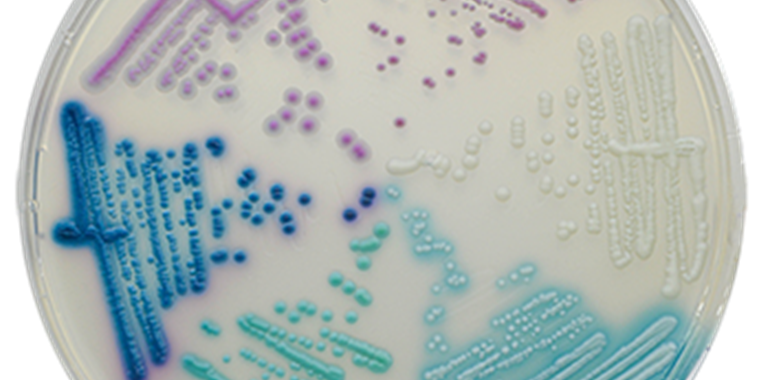

CHROMagar™ Candida Plus zum Nachweis von Candida auris
Experten empfehlen CHROMagar™ Candida Plus zum Nachweis von Candida auris
Diese Expertenmeinung finden Sie hier als Paper im PDF-Format.
Im Jahr 2009 wurde der Hefepilz Candida auris das erste Mal in Japan nachgewiesen und verbreitet sich seitdem stetig. Mittlerweile ist es bereits in England, Spanien und Italien zu Ausbrüchen in Krankenhäusern gekommen. In der 2023 von der Weltgesundheitsorganisation WHO veröffentlichten Liste zur Priorisierung von Pilzen, die Infektionen des Menschen verursachen, wird Candida auris als einer von nur vier Erregern in die höchste Prioritätsstufe gruppiert.
Candida auris ist gegenüber den gängigen Antimykotika resistent. So sind 80 Prozent der am Nationalen Referenzzentrum für Invasive Pilzinfektionen verfügbaren Pilzstämme hoch-resistent gegenüber Fluconazol. Zudem kann der Pilz schnell weitere Resistenzen gegen andere Medikamente entwickeln.
Im Gegensatz zu anderen Pilzen wird Candida auris u.a. durch Schmierinfektionen von Patient zu Patient übertagen und kann so nosokomiale Ausbrüche verursachen. Bislang ist es jedoch schwierig, C.auris zuverlässig im Labor zu identifizieren ist.
Dank des CHROMagar™ Candida Plus gehört die schwierige Identifizierung des Candida auris der Vergangenheit an. Mit einer hohen Spezifität und Sensitivität von 100 % für C.auris-Stämme ist CHROMagar™ Candida Plus ein einzigartiges Medium zur Differenzierung von C.auris gegenüber anderen Candida-Arten.
Aus aktuellem Anlass möchte Mast Diagnostica GmbH als exklusiver und zuverlässiger Partner von CHROMagar™-Produkten, so auch dem einzigartigen CHROMagar Candida Plus, auf folgende Expertenmeinung aufmerksam machen:
Experten des Nationales Referenzzentrums für Invasive Pilzinfektionen (NRZMyk) und des Nationales Referenzzentrum für Surveillance von nosokomialen Infektionen empfehlen CHROMagar™ Candida Plus zum Screening und Nachweis von Candida auris im Kontext nosokomialer Ausbrüche
In der Publikation „Expert recommendations for prevention and management of Candida auris transmission“ empfehlen Prof. Dr. med. Oliver Kurzai (NRZMyk) und andere Experten im Zusammenhang nosokomialer Transmissionen oder Ausbrüchen von Candida auris, die Screening-Proben kulturell mit dem selektiven, chromogenen Medium CHROMagar Candida Plus zu untersuchen, um so die Identifizierung von C.auris zu ermöglichen. Des Weiteren wird empfohlen, einen definierten Work-Flow zur Untersuchung der Screening-Proben in und mit den Diagnostiklaboren zu etablieren. Herkömmliche chromogene Medien weisen C.auris nicht zuverlässig nach. CHROMagar™ Candida zeigt einerseits Wachstum von Candida auris in unterschiedlichen Farbtönen, andererseits wachsen die Kolonien teilweise farblos. Daher wird für die Detektion von Candida auris das spezifische chromogene Medium CHROMagar™ Candida Plus benötigt. CHROMagar™ Candida Plus sollte daher zum Screening und zum kulturellen Nachweis im Kontext (nosokomialer) Ausbrüche zum Einsatz kommen. Von oben betrachtet, wachsen C.auris-verdächtige Kolonien auf diesem Medium in hellblauer Farbe mit einem blauen Hof. Von der Unterseite der Agarplatte zeigen C.auris-Kolonien ein blaues Wachstum. Die Bestätigung der verdächtigen Candida auris-Kolonien kann dann mittels MALDI-TOF direkt von der chromogenen Agarplatte erfolgen.
Den CHROMagar™ Candida Plus erhalten Sie bei uns in folgenden Varianten:
CHROMagar™ Candida Plus Fertigplatten
(gebrauchsfertige Platten, 20 Stück, Art. Nr. 201406)
CHROMagar™ Candida Plus Trockennährmedium
(5 Liter, Art. Nr. 15CA242)
CHROMagar™ Candida Plus Trockennährmedium
(25 Liter, Art. Nr. 15CA243)